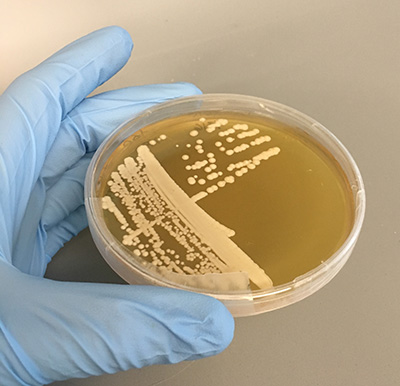

酵母是一种微小的真菌,但它们在从啤酒、奶酪到工业化学品和生物燃料的生产中发挥着关键作用。现在,科学家们提出了一种新的方法,可以帮助这些行业找到新的酵母用于他们的生产过程。
该策略侧重于酵母和昆虫物种之间的关系3月21日发表的一篇论文在英国皇家学会学报B辑:生物科学。本文审查了可用的研究,看看我们对昆虫酵母生态学的理解如何通知寻找工业相关的酵母,特别是在喂食糖,如甲虫,黄蜂,蜜蜂和果蝇等昆虫。
“基于我们对研究的分析,我们认为昆虫和酵母已经发展出了互惠互利的关系,”他说安妮·马登是NC州立大学的博士后研究员和本文的通讯作者。
“酵母以糖为食,有些昆虫也是如此,”Madden说。“一般来说,我们认为昆虫会被酵母的气味所吸引,因为这意味着糖就在附近。当昆虫来觅食时,它们无意中带走了一些酵母。当这些昆虫转向另一个糖源时——一朵花的花蜜,或者腐烂的水果——它们会带走这些酵母。其中一些酵母菌会在一个新的环境中沉淀,那里也有糖。虽然现有的大部分研究集中在单个酵母或昆虫物种(如果蝇),但我们对文献的全面回顾发现,这种互惠互利的现象可能适用于许多不同的昆虫物种和许多类型的酵母。
“这很重要,因为酵母在许多工业应用中都有使用,”Madden说。酵母市场价值超过30亿美元,酵母被用于食品和饮料、生物燃料和饲料添加剂等多个领域。虽然许多工业依赖酵母,但我们在工业上使用的酵母品种很少。
麦登说:“目前至少有1500种酵母,我们认为,了解昆虫生态学以及昆虫与酵母的关系,可以帮助我们识别对工业部门有价值的更好的酵母。”“不仅要使使用中的物种多样化,还要找到非常适合特定应用的菌株。”
例如,行业对可以产生果味和花卉酯或香气的酵母感兴趣。这些是一些相同的特征,使酵母对昆虫具有吸引力。
马登说:“我们已经在昆虫中发现的许多酵母特别擅长自然产生这些蜂蜜和玫瑰的香味。”
研究人员还指出,除了帮助大企业,对这些关系的进一步研究也将有助于我们理解昆虫和酵母的生态和进化。
纸”,昆虫-酵母关系的生态学及其与人类工业的相关性,作者之一丽贝卡·欧文,北卡罗来纳州应用生态学副教授;约翰·谢泼德北卡罗来纳州立大学生物加工科学教授;马格达莱纳佐尔格北卡罗来纳州立大学博士后研究员;罗伯•邓恩,北卡罗来纳州立大学应用生态学教授;玛丽·简·埃普斯,玛丽·鲍德温大学;斯坦福大学的深ami Tadashi。
这项研究得到了美国国家科学基金会1319293号拨款的支持。
- 类别:




